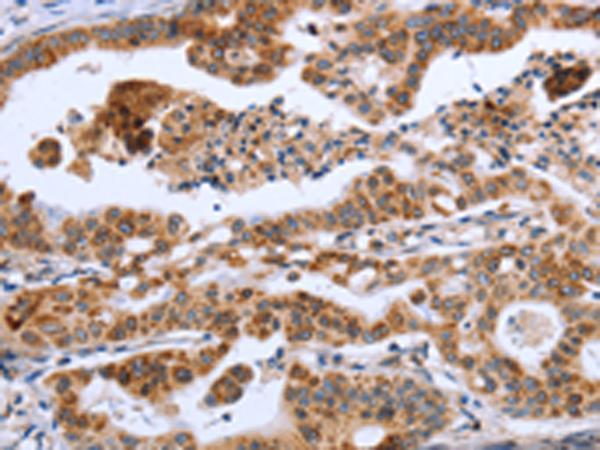
即用型免疫组化抗体

提醒成功
搜索
新闻资讯
News and information-
01-27
2026IRAK4抗体应用:靶点研究与抑制剂开发
IRAK4抗体凭借对靶分子的高特异性识别能力,成为解析靶点生物学特性、推动抑制剂研发的核心工具,为免疫相关疾病的机制研究与诊疗转化搭建起重要桥梁。

-
01-23
2026无载体IL28A纯化抗体
无载体IL28A纯化抗体剔除传统配方中的载体蛋白与防腐剂,以高纯度、低干扰、强兼容性的特质,突破常规抗体应用局限,成为生物医学科研与精准检测领域的重要工具。

-
01-23
2026如何定制高质量的多克隆抗体?
高质量的多克隆抗体能为实验结果的可靠性与准确性提供坚实支撑,而定制过程中的每一个环节都关乎最终产物的品质。科学规划定制流程、规避潜在风险,是获取符合预期抗体的关键所在。

-
01-22
2026配对抗体定制在检测中的关键作用
配对抗体定制打破了通用抗体的应用局限,针对特定检测目标与场景实现性能优化,成为破解复杂检测难题、提升检测体系效能的核心抓手。

-
01-22
2026免疫组化抗体定制服务
精准把控免疫组化抗体定制服务的各关键环节,能为科研与临床应用提供符合需求的高品质试剂,筑牢实验数据的可信度根基。

-
01-21
2026昆虫细胞蛋白表达系统优势全解析
在原核系统修饰能力不足、哺乳动物细胞成本高昂的现实局限下,昆虫细胞蛋白表达系统凭借独特的性能组合,逐步成为科研与工业领域的优选方案

-
01-21
2026抗体测序与重组表达
抗体测序解锁分子结构的遗传密码,重组表达实现功能蛋白的规模化制备,本文将深入剖析两项技术的内在逻辑与应用价值。

-
01-20
2026交叉反应性SAA单抗
交叉反应性SAA单抗凭借对不同物种SAA的特异性识别能力,突破物种壁垒限制,为多物种SAA检测及相关研究提供核心工具。

-
01-20
2026即用型免疫组化抗体
即用型免疫组化抗体凭借经过严苛优化与验证的制备工艺,逐步替代传统浓缩型抗体,成为实验室标准化操作的优选。本文将深入剖析其核心特性。
-
01-19
2026蛋白质免疫印迹检测服务流程与数据解读
本文将梳理蛋白质免疫印迹检测服务流程与科学的数据解读方法,旨在提升实验结果可靠性与研究结论准确性。


微信/QQ登录


首页

